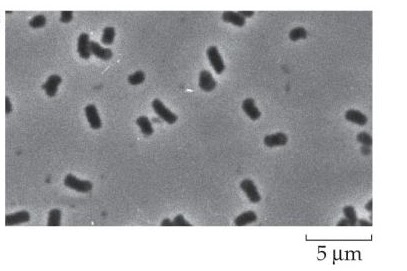

Malodour in treatment facility is one of the commonest problems that bug ETP plants. Most often it is related to disturbed microbial ecology in the plant. Malodour is a phenomenon that occurs frequently in anaerobic systems where conditions have become septic. Two important factors that trigger malodours are very low oxygen levels and absence of nitrates.
Microorganisms degrade cBOD by oxydising componds in presence of electron acceptors. Most microbes are able to use oxygen as a terminal electron acceptor while some can use Nitrates. When both these compounds are absent, microbes turn to alternative electron acceptors. These alternate electron acceptors and by-products of consequent degradation reactions produce compounds that give off malodours. Most of these compounds are sulphur based since sulphur compounds serve as electron acceptors in septic conditions. As a result hydrogen sulphide, dimethyl sulphide, mercaptans etc are formed and released. Along with these, organic acids and alcohols are also formed that add to foul smell.
If the sewage water contains high organic loads and has become septic, then bacteria break down organic molecules into Volatile Organic Compounds and Volatile Fatty Acids along with production of ammonia. When bacteria degarde cBOD in prsence of oxygen or nitrate no foul smelling compound is formed. Only when they switch to alternative electron sources that such foul smelling compounds are produced.
There are several ways to control the problem. One very direct and effective way is to increase oxygen levels. If that is not possible (as in anaerobic treatment plant) the next best solution is to add Nitrates in the wastewater. Nitrates can be added in the form of NaNO3 or Ca(NO3)2. Microbes cannot use sulphur or organic compounds as electron acceptors in presence of oxygen or nitrates.
Bioaggumentation with certain non-pathogenic Pseudomona is also a very good option as these organisms can facultative lower cBOD without production of excess hydrogen sulphide and ammonia.
Chemical methods like addition of alkali or metals salts are temporary. Such methods try reducing malodour by killing all bacteria and stopping anaerobic degradation. These methods are temporary as malodour returns after the effect of these chemicals has subsided and new growth has occurred.
Hydrogen sulphide, common malodour culprit, is also toxic to microbes that reduce ammoniacal nitrogen and it also serves as food source for unwanted filamentous microbes such as Beggiatoa and Thiothrix. Growth of such filamentous organisms leads to scum formation and foaming. Scum formation further complicates the treatment process. The sooner the problem is addressed the better it is.
30.7.11
27.7.11
25.7.11
Floc formation problems and solutions | Getting better flocs biologically
We saw in our last article how bacteria lower COD and BOD (MAR- APR 2011 issue). COD/BOD reduction is achieved by microbial action on organic compounds. However, complete BOD and COD removal is achieved only after microbial biomass settles down as sludge and is removed from the system as sludge.
BOD and COD removal from the system after microbial treatment depends on settling characteristics of the formed sludge. The sludge settling in turn depends on efficiency of floc formation. Floc formation is a highly critical step in effluent treatment deciding its success or failure. Let us try to explore few microbial aspects of floc formation and how microbiology can help us improve the efficiency of our settling tanks.
Flocs could be explained in simple words as aggregates or clusters of microbes which are stuck together. Microbes themselves being very tiny (1-3 microns) do not settle readily in water. Settling needs to be helped by flocculating agents which physically joins them as a single mass to make a floc. These flocculating agents help in clustering these microbes into a single particle improving floc settling. Some microbes have the natural ability to make these flocculating agents and secrete them in water. Use of such microbes in the product helps in achieving good flocculating characters naturally.
Some of the microbial genera that are known to enhance floc formation include Bacillus, Achromobacter, Citromonas Aerobacter , Alcaligenes , Flavobacterium Arthrobacter , Zoogloea . Bacterial surfaces are known to harbour protein moieties on their surface. These protein moieties have COOH groups and OH groups on their surface. COOH groups and OH groups become charged by losing an H ion. These charged COO- groups and O- groups give a net negative charge to the bacterial surface. If positively charged divalent calcium2+ ions are present in effluent water, they serve in aggregating negatively charged bacteria.
Microbes then further enhance flocculation by production of polymers. Bacterial polymers serve both as floc backbone and a binding network that holds bacteria. Bacteria majorly produce two types of polymers, starch and Polyhydroxybutrate. Starch (a polymer of sugars) is produced and secreted externally. This starch envelopes the bacteria as well as neighboring cells holding them together.
Young bacterial cells produce liberally spaced loose mass of starch. Whereas old bacterial cells produce tightly bound dense polymer network of starch leading to a denser and stable floc.
Production of Polyhydroxybutrate (PHB) by some bacteria further strengthens the floc. PHB serves as a food source for bacteria. It is stored both internally and externally by the bacteria. PHB helps in anchoring bacterial cell flocs together. Being significantly denser then starch polymers, PHB increases the floc density and leads to faster settling.
Filamentous microbes too play an important role in floc formation. Such microbes when present in right levels significantly improve floc formation and floc stability. Filaments serve as backbone to the floc. Filamentous microbes start to appear in floc at later stages.
Young flocs, which do not have filamentous microbes, appear spherical when seen under the microscope. While older flocs, having a network filaments throughout them, appear irregular in shape. Microbial observation is a quick and conclusive method to check floc formation the efficiency of the effluent plant. Generally, floc formation and settling proceeds well under neutral to slightly alkaline conditions. Acidic conditions may lead to uncontrolled growth of filamentous fungi leading to "bridging of flocs."
This not only reduces floc setting efficiency but also leads to foaming problems.
So to achieve good flocculation one must ensure presence of starch and PHB secreting bacteria and a few filamentous microbes in the effluent treatment plant. With right conditions and right microbes floc formation is a settled matter.
BOD and COD removal from the system after microbial treatment depends on settling characteristics of the formed sludge. The sludge settling in turn depends on efficiency of floc formation. Floc formation is a highly critical step in effluent treatment deciding its success or failure. Let us try to explore few microbial aspects of floc formation and how microbiology can help us improve the efficiency of our settling tanks.
Flocs could be explained in simple words as aggregates or clusters of microbes which are stuck together. Microbes themselves being very tiny (1-3 microns) do not settle readily in water. Settling needs to be helped by flocculating agents which physically joins them as a single mass to make a floc. These flocculating agents help in clustering these microbes into a single particle improving floc settling. Some microbes have the natural ability to make these flocculating agents and secrete them in water. Use of such microbes in the product helps in achieving good flocculating characters naturally.
Some of the microbial genera that are known to enhance floc formation include Bacillus, Achromobacter, Citromonas Aerobacter , Alcaligenes , Flavobacterium Arthrobacter , Zoogloea . Bacterial surfaces are known to harbour protein moieties on their surface. These protein moieties have COOH groups and OH groups on their surface. COOH groups and OH groups become charged by losing an H ion. These charged COO- groups and O- groups give a net negative charge to the bacterial surface. If positively charged divalent calcium2+ ions are present in effluent water, they serve in aggregating negatively charged bacteria.
Microbes then further enhance flocculation by production of polymers. Bacterial polymers serve both as floc backbone and a binding network that holds bacteria. Bacteria majorly produce two types of polymers, starch and Polyhydroxybutrate. Starch (a polymer of sugars) is produced and secreted externally. This starch envelopes the bacteria as well as neighboring cells holding them together.
Young bacterial cells produce liberally spaced loose mass of starch. Whereas old bacterial cells produce tightly bound dense polymer network of starch leading to a denser and stable floc.
Production of Polyhydroxybutrate (PHB) by some bacteria further strengthens the floc. PHB serves as a food source for bacteria. It is stored both internally and externally by the bacteria. PHB helps in anchoring bacterial cell flocs together. Being significantly denser then starch polymers, PHB increases the floc density and leads to faster settling.
Filamentous microbes too play an important role in floc formation. Such microbes when present in right levels significantly improve floc formation and floc stability. Filaments serve as backbone to the floc. Filamentous microbes start to appear in floc at later stages.
Young flocs, which do not have filamentous microbes, appear spherical when seen under the microscope. While older flocs, having a network filaments throughout them, appear irregular in shape. Microbial observation is a quick and conclusive method to check floc formation the efficiency of the effluent plant. Generally, floc formation and settling proceeds well under neutral to slightly alkaline conditions. Acidic conditions may lead to uncontrolled growth of filamentous fungi leading to "bridging of flocs."
This not only reduces floc setting efficiency but also leads to foaming problems.
So to achieve good flocculation one must ensure presence of starch and PHB secreting bacteria and a few filamentous microbes in the effluent treatment plant. With right conditions and right microbes floc formation is a settled matter.
How do Bacteria lower COD and BOD? | Basics in simple language
Have you ever wondered how bacteria reduce COD and BOD? Wonder no more. Here is a simplified sketch on the process. Bacteria, though smaller than few microns, are the main workforce inside the ETP. A healthy ETP system has a good dose of right bacteria in it to eat away pollutants. The key word here is “right bacteria. “ But what does one mean by “right bacteria”? How do bacteria eat those pollutants? Do they have microscopic mouth and teeth to chew on chemicals? Let’s understand few basics of microbiology to answer this question.
First thing we ought to know is that bacteria are different than terrestrial animals. They do not have distinct body parts like mouth, eyes, ear, brain, heart nervous system etc. They are more like tiny bags full of biochemicals. Chemicals move in and out of bacteria through small pores on the bacterial surface. Infact microbes are more than a mere porous bag of biochemicals. They are more like a chemical factory where more than 100’s of different chemical reactions are taking place simultaneously.
All these reactions are happening in the same vessel at ambient temperature and neutral pH. These reactions do not interfere with each other nor do they produce any byproducts! So what is this bacterial factory producing? It’s producing parts to assemble a new complete factory out of itself. A biochemical factory that re-produces itself. Isn’t that exciting? And this is what all life forms do. This is what all biochemical reactions inside bacteria are geared to do. To enable an organism to make copies of itself and continue its species.
Biochemical reactions happening inside the bacteria can be divided in to two separate categories. Catabolic reactions and Anabolic reactions. Catabolic reactions lead to breakdown of complex chemical compounds in to smaller simpler components. Anabolic reactions lead to joining of these monomers to make complex compounds. These both happen inside the bacteria simultaneously. So why is a bacteria breaking down complex compounds and rebuilding them again? Confused? Let’s consider an analogy to understand this. It’s like you have a huge godown in front of you and you want to break down that godown and build your office there instead. So you start with first breaking that godown to clear space. But while you do that you break it down neatly to take out intact bricks from the wall, separate glass-panes from the windows without breaking any, uproot tiles without breaking them and then store them neatly in stacks for reuse. You break down the godown and get all building blocks separated and then reuse those parts to build an entirely new building, the office. Those bricks in the office wall, those tiles on the floor are all the same but the building is different. It’s because the design is different. The design is different because your engineer used the blueprint of an office design and not of a godown.
Bacteria grow in this way. They take complex chemical compounds and break them in simpler smaller monomers that are then reused to build biological molecules (called macromolecules) for the bacterial growth. So do bacteria have a blueprint like we do to build a building? Yes, and that’s the DNA. It is the DNA that decides all the characters of the bacteria. Just like the blueprint decides the characteristics of the building.
Once the bacteria builds enough macromolecules to build a new microbe it then makes two copies of the DNA and then splits the cell into two parts each part receiving one copy of DNA and those newly made macromolecules. The cycle goes on forever doubling bacteria everytime.
As a result of this, chemicals in water are taken up by bacteria to be broken down and reassembled into bacterial components. These bacteria settle down as sludge leading to decrease in COD and BOD of the effluent. Pollutants are converted into bacterial biomass. The most critical step here is the breakage of the chemical compounds in to simpler ones.
Most of the bacteria are similar in their anabolic pathways but they differ in their catabolic pathways. Bacteria vary in their ability to break down different chemical compounds. Specific bacteria are better than others for breaking down specific type of compounds. Hence, to get effective degradation one must consider applying a consortium of microbes capable of complete digestion rather than using a single bug system.
First thing we ought to know is that bacteria are different than terrestrial animals. They do not have distinct body parts like mouth, eyes, ear, brain, heart nervous system etc. They are more like tiny bags full of biochemicals. Chemicals move in and out of bacteria through small pores on the bacterial surface. Infact microbes are more than a mere porous bag of biochemicals. They are more like a chemical factory where more than 100’s of different chemical reactions are taking place simultaneously.
All these reactions are happening in the same vessel at ambient temperature and neutral pH. These reactions do not interfere with each other nor do they produce any byproducts! So what is this bacterial factory producing? It’s producing parts to assemble a new complete factory out of itself. A biochemical factory that re-produces itself. Isn’t that exciting? And this is what all life forms do. This is what all biochemical reactions inside bacteria are geared to do. To enable an organism to make copies of itself and continue its species.
Biochemical reactions happening inside the bacteria can be divided in to two separate categories. Catabolic reactions and Anabolic reactions. Catabolic reactions lead to breakdown of complex chemical compounds in to smaller simpler components. Anabolic reactions lead to joining of these monomers to make complex compounds. These both happen inside the bacteria simultaneously. So why is a bacteria breaking down complex compounds and rebuilding them again? Confused? Let’s consider an analogy to understand this. It’s like you have a huge godown in front of you and you want to break down that godown and build your office there instead. So you start with first breaking that godown to clear space. But while you do that you break it down neatly to take out intact bricks from the wall, separate glass-panes from the windows without breaking any, uproot tiles without breaking them and then store them neatly in stacks for reuse. You break down the godown and get all building blocks separated and then reuse those parts to build an entirely new building, the office. Those bricks in the office wall, those tiles on the floor are all the same but the building is different. It’s because the design is different. The design is different because your engineer used the blueprint of an office design and not of a godown.
Bacteria grow in this way. They take complex chemical compounds and break them in simpler smaller monomers that are then reused to build biological molecules (called macromolecules) for the bacterial growth. So do bacteria have a blueprint like we do to build a building? Yes, and that’s the DNA. It is the DNA that decides all the characters of the bacteria. Just like the blueprint decides the characteristics of the building.
Once the bacteria builds enough macromolecules to build a new microbe it then makes two copies of the DNA and then splits the cell into two parts each part receiving one copy of DNA and those newly made macromolecules. The cycle goes on forever doubling bacteria everytime.
As a result of this, chemicals in water are taken up by bacteria to be broken down and reassembled into bacterial components. These bacteria settle down as sludge leading to decrease in COD and BOD of the effluent. Pollutants are converted into bacterial biomass. The most critical step here is the breakage of the chemical compounds in to simpler ones.
Most of the bacteria are similar in their anabolic pathways but they differ in their catabolic pathways. Bacteria vary in their ability to break down different chemical compounds. Specific bacteria are better than others for breaking down specific type of compounds. Hence, to get effective degradation one must consider applying a consortium of microbes capable of complete digestion rather than using a single bug system.
23.7.11
Different Waste water Bacteria growing on petriplates
| ||
Here are some images/pictures of bacteria growing on an petriplates that an effluent treatment manager may find useful.
22.7.11
Fecal Contamination indicator organisms found in wastewater.
Fecal Contamination indicator organisms are bacteria usually found in feces. Presence of these organisms is usually taken as an indication of the waste-water being contaminated by feces. This increases chances of the water being contaminated by pathogens such as Salmonella, Shigella, Proteus etc. These organisms can be detected by methods given in US or British Pharmacopoeia. Images shown here may help you in identifying these colonies on agar plates.
![]() |
| Coliform growing on Eosin Methylene Blue agar. Coliforms show shiny metallic green colour |
21.7.11
Bacteria to treat Ammonical Nitrogen and Total Nitrogen in Wastewater
These bacteria are known to play a significant role in reduction of nitrogen levels in effluent. Images as seen under microscope.
![]() |
| Nitrite Oxydising bacteria (NOB) Nitrospira |
![]() |
| Ammonia oxydising bacteria (AOB) Nitrosolobus |
![]() |
| Ammonia oxydising bacteria (AOB) Nitrosomona |
![]() |
| Nitrite Oxydising bacteria (NOB) Nitrococcus |
20.7.11
Common bacteria, fungi and protozoa found in wastewater.
Stalked Ciliated protozoa
Amobea
Beggiatoa
Cilliate
Crawling Cilliate
Euglena
Microthrix parvicella
Nematode
Fungal filatments
Bacillus and its spores as seen in gram stain slide
Rotifer
Rotifer
Rotifer
Rotifer
18.7.11
Wastewater bacteria database (free download)
Bacteria in wastewater plant are like small Nano engines that drive the process of effluent treatment. Having the right type of bacteria in right quantities is of utmost importance in treating the waste. Unwanted microorganisms like some filamentous fungi and bacteria can have drastic effect on plant condition. Foaming, malodors, inefficient COD removal, pH imbalance are some of the consequences of having inefficient microbes in the treatment tank.
Ability to identify different bacteria and fungi will help waste water treatment plant operator to co-relate the reasons of any upsets in the plant with the bacteria present in it. Plant operators in such cases can take an informed decision and rectify the situation. Conditions in the waste water treatment tank need to be maintained favorable for beneficial microbes to grow and degrade pollutants in the effluent at the same time these conditions should also inhibit unwanted microbes from proliferating in the wastewater treatment tank.
Here we are providing a small database of different types of wastewater bacteria with their microscopic characters and their effect on effluent treatment process. This database can be used to observe and compare microbes present in your effluent with those shown in this database. All you need is a simple microscope and sufficient skill to use it properly. If you are new to using microscopes, then I would suggest reading the \\\\\ How to use microscope?\\\ article.
You're free to download waste water bacteria database for your personal use. I request you to quote reference (or link) to this blog if you intend to use it for publishing online or offline. I hope that you will understand the amount of effort that went into building this waste water organism database and presenting it online free for you. I do not claim this database to be complete in all sense. However, I will try to make it as useful as possible for you as we go ahead. I'll be delighted to hear your suggestions to make it better. The database is characterized on the basis of wastewater bacteria types and their effects in wastewater treatment process.
Ability to identify different bacteria and fungi will help waste water treatment plant operator to co-relate the reasons of any upsets in the plant with the bacteria present in it. Plant operators in such cases can take an informed decision and rectify the situation. Conditions in the waste water treatment tank need to be maintained favorable for beneficial microbes to grow and degrade pollutants in the effluent at the same time these conditions should also inhibit unwanted microbes from proliferating in the wastewater treatment tank.
Here we are providing a small database of different types of wastewater bacteria with their microscopic characters and their effect on effluent treatment process. This database can be used to observe and compare microbes present in your effluent with those shown in this database. All you need is a simple microscope and sufficient skill to use it properly. If you are new to using microscopes, then I would suggest reading the \\\\\ How to use microscope?\\\ article.
You're free to download waste water bacteria database for your personal use. I request you to quote reference (or link) to this blog if you intend to use it for publishing online or offline. I hope that you will understand the amount of effort that went into building this waste water organism database and presenting it online free for you. I do not claim this database to be complete in all sense. However, I will try to make it as useful as possible for you as we go ahead. I'll be delighted to hear your suggestions to make it better. The database is characterized on the basis of wastewater bacteria types and their effects in wastewater treatment process.
15.7.11
Welcome to Wastewater Bacteria.
Wastewater bacteria is all about microbes in wastewater and their impact on effluent treatment process.
Hope you enjoy reading it.
Hope you enjoy reading it.
Subscribe to:
Comments (Atom)